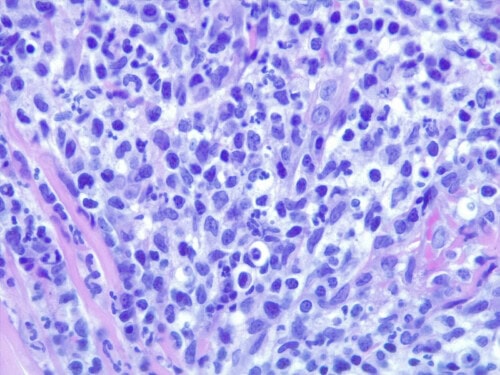
Discussion à propos d’un cas de dermatite lichénoïde psoriasiforme atypique chez une chienne Fox-Terrier.

Une chienne croisée Fox terrier âgée de 9 ans est présentée en consultation pour une dermatite multifocale prurigineuse évoluant depuis plusieurs mois, avec réponse partielle à divers traitements anti-infectieux et anti-inflammatoires.
Jean-Loup Mathet
Octobre 2025
Divers cas de dermatite lichénoïde ont déjà été déjà été décrits sur Dermavet par les Drs Thomas Brément, Emmanuel Bensignor ou Eric Florant, mais également William Bordeau (Le Point Vétérinaire, 2008). Ce cas clinique ne présente pas d’originalité particulière mais est l’occasion de discuter de l’étiologie, de la pathogénie de cette entité inhabituelle, mais aussi de revenir rapidement sur le psoriasis de l’homme.
Commémoratifs et anamnèse
La chienne vit exclusivement en milieu rural, sans congénère. Elle reçoit un aliment industriel de qualité, chasse régulièrement et n’a jamais voyagé. Ses traitements antiparasitaires externes mensuels (afoxolaner), internes (milbémycine et praziquantel), ainsi que ses vaccins sont à jour.
Elle présente initialement des lésions cutanées très prurigineuses, circulaires, alopéciques et croûteuses, sur les membres et les flancs, évocatrices de teigne. Un traitement oral antibiotique (ac clavulanique + amoxicilline) et corticoïde (prednisolone) est prescrit par le vétérinaire traitant. Y sont associées des lotions d’énilconazole (Imaveral) appliquées sans que le propriétaire ne respecte les consignes d’utilisation. Dans les semaines suivantes les croûtes se généralisent, et le prurit s’aggrave.
Un bilan biochimique est dans les valeurs usuelles. Face à dégradation clinique et en l’absence de réponse thérapeutique la chienne nous est référée.
Examen clinique
Il met en évidence des plaques croûteuses en relief, épaissies, plus ou moins coalescentes, hyperkératosiques, squameuses et parfois érosives péri-oculaires, accompagnées d’un squamosis abondant des pavillons auriculaires sur leur face externe et les oreillons.
Les membres et les pieds présentent des zones érosives voire suintantes. Une masse douloureuse granulomateuse déforme également un coussinet. Une zone d’aspect plutôt ulcératif est présente sur l’une des paupières. (photos 1 à 4)
1 – lésion croûteuse ulcérative (disséminées sur le pelage)
2 – érosion à bords squameux à la jonction d’un coussinet
3 – plaques ulcératives sur un membre postérieur
4 – ulcération palpébrale
Le prurit est intense notamment au niveau facial et podal, et nécessite le port d’une collerette depuis plusieurs semaines.
Hypothèses diagnostiques
Le diagnostic différentiel inclus une mycose superficielle en particulier une dermatophytie, une pyodermite, un pemphigus foliacé ou érythémateux, un trouble de la kératinisation primaire, une dermatite lichénoïde sl (kératose lichénoïde, dermatite lichénoïde idiopathique ou psoriasiforme), une toxidermie, voire un lymphome cutané au vu de l’âge de l’animal. Une leishmaniose est moins probable.
Examens complémentaires
Les cytologies sous-crustacées montrent des images de phagocytose bactérienne (cocci). La chienne ne recevant plus d’antifongiques depuis plusieurs semaines, une culture mycologique est demandée, elle est positive pour quelques colonies de levures Malassezia.
Un examen histopathologique est demandé au LAPVSO (Dr Frédérique DEGORCE). Les biopsies mettent en évidence des lésions surélevées focales en plaques, caractérisées par une une hyperplasie psoriasiforme, épidermique, avec spongiose, œdème des acanthocytes et une forte exocytose de granulocytes neutrophiles, évoluant en pustules granulocytaires sous et intra-cornées qui s’impétiginisent. Dans le derme sous-jacent un infiltrat forme une plage cellulaire d’allure lichénoïde, les cellules se collectant sous la membrane basale épidermique et entourant les apex folliculaires. L’infiltrat cellulaire est formé de granulocytes neutrophiles, de cellules histiocytoïdes et petits lymphocytes et de plasmocytes. Une vésiculation hydropique est présente à l’interface des structures épithéliales ainsi que quelques corps apoptotiques dans leur couche basale. Aucun élément figuré, ni parasitaire, ni fongique n’a été détecté sur les différents plans de section effectués, ni sur la réaction au PAS. (photos 5 à 8)
Photos 5 : HES*630 gros plan sur l’infiltrat cellulaire formé de granulocytes neutrophiles, cellules histiocytoïdes, lymphocytes et plasmocytes
Photos 6 et 7 : HES*200 plage cellulaire d’allure lichénoïde et pustule granulocytaire sous et intra-cornée, vésiculation hydropique à l’interface des structures épithéliales et corps apoptotiques dans la couche basale
Photo 8 :HES*25 hyperplasie psoriasiforme, épidermique, infiltrat cellulaire d’allure lichénoïde et pustules granulocytaires sous et intra-cornées
Au vu de la clinique, de la présence de lésions multiples et de l’aspect histologique, l’hypothèse d’une dermatose lichénoïde psoriasiforme est retenue plutôt que celle d’une kératose lichénoïde.
Traitement et évolution
Une antibiothérapie probabiliste à base de céfalexine 30mg/kg en deux prises quotidiennes est débutée (THERIOS ND) associée à l’application topique d’acide fusidique deux fois par jour, une dizaine de jours (FORUDINE ND) sur les lésions les plus sévères. L’amélioration étant rapide, la céfalexine est poursuivie après la disparition complète des lésions, soit 5 semaines en tout.
Discussion
La dermatite lichénoïde psoriasiforme est une forme d’éruption maculeuse unilatérale ou symétrique pouvant intéresser typiquement la face interne et parfois externe des pavillons auriculaires et éventuellement l’abdomen, la région caudo-ventrale de l’abdomen, la région prépuciale, périanale ou éventuellement le pourtour oculaire ou labial ou encore les extrémités des membres. Ce type d’éruption est susceptible de régresser spontanément.
Initialement décrite dans la race Springer Spaniel, cette dermatose a été observée dans d’autres races canines, en particulier après prise prolongée à dose élevée de ciclosporine : Pointer, Setter anglais, Caniche, West highland white terrier, Shih Tzu.
L’étiopathogénie est inconnue, une médiation immunitaire et/ou infectieuse est suspectée. Les spécialistes s’accordent maintenant à considérer cette dermatose comme une modalité réactionnelle cutanée traduisant une stimulation immunitaire excessive en réponse à une infection bactérienne en général staphylococcique, confirmée d’une part par la visualisation fréquente de bactéries cocciformes dans les couches supérieures de l’épiderme, et d’autre part par une amélioration clinique rapide lors d’antibiothérapie. Dans ce cas de figure précis, on peut évoquer davantage une pyodermite lichénoïde comme proposé par E. Bensignor dans la description d’un cas chez un Fox-Terrier (2016, Dermavet).
A noter que d’autres antigènes déclenchants sont suspectés comme une infection virale ou une réaction médicamenteuse.
Chez les chiens de chasse, le rôle de microtraumatismes cutanés superficiels et répétés en action de chasse est fortement suspecté. Cette constatation est évocatrice du phénomène de Koebner parfois initiateur dans le psoriasis humain, et se traduit par l’apparition de lésions cutanées typiques d’une dermatose préexistante sur une peau préalablement saine, suite à un traumatisme local (grattage, coupure, tatouage…).
Chez le chien, il a aussi été décrit des cas induits par la ciclosporine : les lésions apparaissent en général en 4 à 6 semaines et peuvent régresser à l’arrêt ou à la diminution de la posologie de la molécule.
La définition histologique de l’entité est ici confirmée par la présence de pustules intraépidermiques éosinophiliques et neutrophiliques, d’une bande lichénoïde conséquence d’une infiltration inflammatoire dense principalement lymphocytaire ou plasmocytaire à la jonction dermo-épidermique, et enfin d’une allure psoriasiforme de l’épiderme caractérisée par une hyperplasie régulière, des crêtes épidermiques et une spongiose similaire aux observations lors de psoriasis chez l’homme. L’apoptose kératinocytaire est plus rare et équivoque.
A noter dans notre cas que la colonisation par des levures Malassezia a été détectée à la culture mais pas au PAS.
Les dermatoses lichénoïdes ou dermatites d’interface chez le chien regroupent le lupus érythémateux, la dermatomyosite, l’érythème polymorphe, un pemphigus foliacé débutant, certains cas de pyodermites des jonctions cutanées, et parfois une leishmaniose lors d’atteinte du planum nasal. L’aspect psoriasiforme, qui est un terme descriptif clinique, est quand à lui retrouvé lors de certains troubles de la kératinisation (ichtyose, séborrhées primaires ou secondaires), les formes chroniques de dermatites à Malassezia (ex « dysplasie épidermique du WHWT) et dans les cas dermatite atopique ancienne.
La prise en charge passe donc d’abord par une antibiothérapie raisonnée et prolongée lors de réponse positive, éventuellement confortée par une culture bactériologique sur biopsies lors d’échec initial. Les soins topiques antiseptiques et antiséborrhéiques apportent une aide complémentaire. Certains cas peuvent répondre a contrario à un traitement corticoïde, mais il est alors davantage probable qu’il s’agisse d’une dermatose lichénoïde psoriasiforme sensus stricto et pas d’une « pyodermite lichénoïde ».
Le diagnostic de cette entité rare et mal comprise repose sur l’analyse des signes cliniques et de leur distribution, une histopathologie évocatrice et le plus souvent une réponse à une antibiothérapie adaptée.
A propos du psoriasis humain
Le psoriasis est une dermatose inflammatoire chronique de la peau qui touche environ 2 % de la population française. Dans environ 20 % des cas, il se complique avec l’apparition de manifestations articulaires : les rhumatismes psoriasiques. Maladie multifactorielle, ses mécanismes physiopathologiques font intervenir des facteurs génétiques, environnementaux (infection, stress local ou psychologique…), microbiologiques et immunologiques. Une réaction tissulaire psoriasiforme est également suspectée en réponse à l’action des « superantigènes » bactériens.
Si le psoriasis peut survenir à tout âge, il existe deux principaux pics d’apparition : à l’adolescence puis vers la cinquantaine. Environ un tiers des cas se déclarent avant 20 ans, y compris chez des personnes très jeunes. Les débuts précoces ne sont pas plus sévères, mais ils sont associés à davantage de récidives. L’évolution de la maladie est imprévisible et progresse par poussées d’intensité variable, entrecoupées de rémissions de durée également variable. Il peut s’écouler plusieurs années entre deux poussées.
Le psoriasis est dû à un dérèglement et un emballement immunitaire qui entraîne une inflammation chronique et exagérée cutanée puis une prolifération kératinocytaire. Suite à l’exposition à différents facteurs déclenchants, le système immunitaire inné s’active anormalement, produit des molécules inflammatoires (interférons, IL-23…) qui recrutent dans la peau des lymphocytes T activés et des polynucléaires neutrophiles. Ces cellules produisent à leur tour localement d’autres molécules inflammatoires (cytokines IL-17, IL-22, TNF-α…) qui auto-entretiennent l’inflammation et stimulent la production des kératinocytes. Le délai de renouvellement de ces cellules, de trois semaines en temps normal, passe alors à trois jours, d’où l’hyperkératose.
Cliniquement, le psoriasis est caractérisé par des plaques érythémato-squameuses habituellement localisées au niveau des zones de frottement (coudes, avant-bras, genoux, bas du dos) mais aussi sur le cuir chevelu, les parties génitales, les mains ou les pieds et les ongles. Toutefois, ces plaques peuvent apparaître n’importe où, y compris sur les muqueuses. Elles peuvent se généraliser et s’étendre sur de grandes surfaces du corps.
Plusieurs formes cliniques de la maladie existent, parmi lesquelles :
– le psoriasis en plaques ou psoriasis vulgaris, présentation la plus fréquente caractérisée par des plaques bien délimitées, à des bords nets, en relief, peuvent présenter une guérison centrale, témoin de l’activité périphérique des plaques. Elles sont le plus souvent indolores, mais elles peuvent entraîner des démangeaisons et se fissurer.
– le psoriasis en goutte, caractérisé par de plaques de petite taille, nombreuses et en forme de larmes. Il est principalement rencontré chez l’enfant et le jeune adulte, classiquement à la suite d’une infection des voies aériennes supérieures.
– le psoriasis pustuleux, est une forme plus rare mais plus souvent résistante aux traitements, plutôt familiale, se manifestant par des pustules ou des plaques inflammatoires pustuleuses pouvant être localisées aux paumes et aux plantes de pieds ou bien généralisées, ce qui conditionne la gravité de la maladie.
Un terrain génétique est suspecté et augmenterait la sensibilité du système immunitaire, en abaissant le seuil de déclenchement de l’inflammation face à des facteurs déclenchants comme les frottements, le stress, un choc émotionnel ou un traumatisme, des modifications climatiques, une infection, la consommation d’alcool ou encore la prise d’un médicament. Ces facteurs déclenchants peuvent être différents d’un individu à un autre et varier au cours de la vie du patient.
Il n’existe aujourd’hui aucun traitement qui permette de guérir du psoriasis. Toutefois, il est possible d’en réduire considérablement les symptômes et d’améliorer la qualité de vie des patients. Ces traitements symptomatiques doivent être pris en continu pour éviter les rechutes.
On distingue des traitements locaux adaptés aux formes peu étendues (dermocorticoïdes) ou en complément des autres thérapeutiques systémiques (immunosuppresseurs, méthotrexate, acitrétine ou encore ciclosporine) dans les formes sévères, parfois associés à la PUVA thérapie et à un dérivé de la vitamine D3
En l’absence de réponse à au moins deux de ces traitements les biothérapies – injections d’anticorps monoclonaux – offrent le plus souvent des résultats remarquables sur les psoriasis résistants et les rhumatismes psoriasiques.
Chez l’homme, le retentissement du psoriasis sur la qualité de vie et la santé mentale des patients étant important, de nombreux travaux sont en outre conduits afin d’affiner et optimiser les stratégies thérapeutiques et prédire leur efficacité dans un contexte où les traitements doivent être prescrits de manière prolongée.
Remerciements au Dr Frédérique DEGORCE (LAPVSO) pour l’examen histopathologique et pour les clichés microscopiques.
Bibliographie
D.W. Scott, W.H. mille rand C.E. Griffin : Muller and Kirk’s Small Animal Dermatology, W.B. saunders company, Philadelphia, 6th edition, 2001, p.929-931.
Ihrke PJ, Walder EJ, Affolter VK. Hyperplastic diseases of the epidermis. In: Gross TL, ed. Skin diseases of the dog and cat. 2nd ed. Ames, Iowa: Blackwell Science Ltd, 2005;152–154.
Banovic F., Olivry T. in Vet Med Today : Pathology in practice. JAVMA .2014, 245(11), 1237-1239.
Favrot., Olivry T. et al. Causal heterogeneity of cyclosporine-induced verrucous skin lesions in dogs. Abstracts of the ACVD AAVD Congress, Florida, 2005 in Vet. Derm. 16, p192.
Levy : Les génodermatoses de l’épiderme, de la jonction dermo-épidermique et des annexesfolliculaires du chien. Thèse n° 7, 2005, Ecole nationale Vétérinaire de Lyon et Université Claude Bernard- Lyon I, p81 à 84.
K.V. Mason, R.E . Halliwell, B.J. McDougal : Characterization of lichenoid-psoriasiform dermatosis of springer spaniels. J. Am. Vet. Med. Assoc., 1986,189(8) , 897-901.
A.H. Werner : Psoriasiform-lichenoid-like dermatosis in three dogs treated with microemulsified cyclosporine A. J. Am. Vet. Med. Assoc., 2003, 223(7) , 1013-1016.
Seibel W, Sundberg, JP, Lesko LJ, et al. Cutaneous papillomatous hyperplasia in cyclosporine-A treated beagles. J Invest Dermatol 1989; 93 : 224-230.
Bordeau W, Un cas de dermatose lichénoïde psoriasiforme, Le Point Vétérinaire, 2008, 285 : 61-65.
Degorce F, Les dermatites lichénoïdes. Proc Journées Annuelles du GEDAC, 2003, 157-158, Bercy